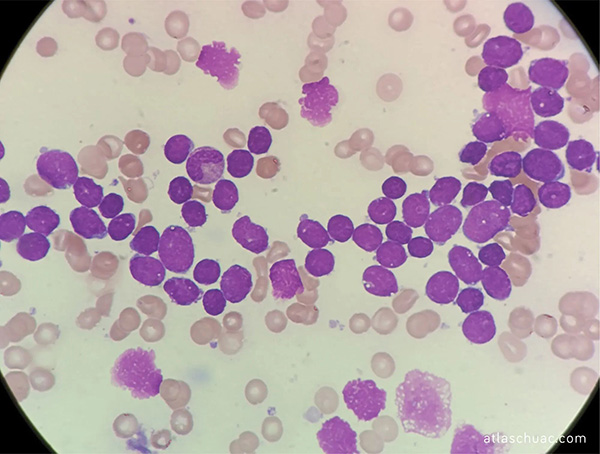

【健康科普】三个月的宝宝贫血身上有出血点,一查竟是白血病!
作为一名儿童血液科医生,每天都在和孩子们的血液健康打交道,见过太多因忽视早期信号而延误诊疗的遗憾案例。就在近日,我们接诊了一位仅三个月大的小婴儿,宝宝因为皮肤出现不明原因的出血点前来就诊,这种现象已经反复出现近1个月了。完善血常规检查后,提示贫血、血小板明显减少,进一步做骨髓穿刺检查,最终确诊为儿童先天性白血病。

这个结果让家长悲痛不已,也让我们无比揪心。这么小的孩子,本该在家人的呵护下健康成长,却遭遇如此重疾。而这一病例,也再次给所有家长敲响警钟:宝宝的血常规报告绝非简单的数字,每一项指标异常都可能暗藏健康危机,儿童先天性白血病更需早警惕、早发现、早干预!
先读懂:什么是儿童先天性白血病?
很多家长对“先天性白血病”十分陌生,甚至从未听过这个疾病,其实它是一种罕见却凶险的儿童血液恶性肿瘤。医学上,先天性白血病指的是宝宝出生至生后4~6周内发生的白血病,属于婴儿白血病的特殊类型,发病率极低,仅占存活婴儿的4.7/100万,在所有儿童急性白血病中占比1/1000。
它的发病核心是骨髓造血干细胞发生恶性克隆增殖,大量异常白血病细胞在骨髓内疯狂生长,挤占正常造血空间,导致正常红细胞、白细胞、血小板生成不足,进而引发一系列症状,且病情进展极为迅速,若不及时诊治,会严重危及宝宝生命。目前先天性白血病的病因尚未完全明确,主要和遗传基因缺陷、宫内环境因素密切相关:比如宝宝自身存在染色体异常、先天基因缺陷;妈妈孕期接触电离辐射、苯类等有毒化学物质、滥用药物,或是发生宫内病毒感染等,都可能增加宝宝患病风险。
别忽视先天性白血病的早期信号,家长一定要记牢!

三个多月的小婴儿,无法用语言表达身体不适,家长日常一定要细心观察,出现这些异常,务必第一时间就医检查:
1.贫血相关表现:宝宝面色、口唇、指甲持续苍白,精神萎靡、不爱活动、吃奶无力、嗜睡,生长发育迟缓,这是因为正常红细胞不足,身体无法获得充足氧气。
2.出血倾向:这是非常典型的信号!皮肤出现针尖样出血点、瘀斑,可能遍布全身;部分宝宝还会出现牙龈渗血、鼻出血,严重时甚至有消化道、颅内出血,根源是血小板数量大幅减少,凝血功能失常。
3.反复发热:不明原因的发热,体温忽高忽低,普通抗感染治疗效果差,这是因为异常白血病细胞抑制了正常免疫细胞,宝宝抵抗力极度低下,极易合并感染,或是疾病本身引发的肿瘤热。
4.器官浸润表现:部分宝宝会出现肝脾肿大,腹部莫名膨隆;皮肤出现结节、丘疹;少数还会有呼吸急促、呕吐、抽搐等脏器受累表现。
关键提醒:血常规是筛查第一道防线,别忽略指标异常!
很多家长带宝宝体检时,拿到血常规报告,只看有没有贫血、白细胞高不高,却对血小板减少、异常细胞提示等关键信息视而不见,这也是导致疾病延误的重要原因。血常规是排查白血病最基础、最关键的检查,这几项指标一定要重点关注:
- 血红蛋白:明显低于同龄宝宝正常范围,提示贫血;
- 血小板计数:显著减少,是出血的核心原因,绝不能轻视;
- 白细胞:数值可能升高、降低或正常,但外周血涂片往往能发现异常幼稚细胞,这是白血病的重要线索。
在此郑重提醒:不要觉得宝宝小、没大碍就忽视血常规检查,也不要拿到报告后不找专业医生解读,自行判断、心存侥幸。一旦发现上述指标异常,一定要遵医嘱进一步做外周血涂片、骨髓穿刺等检查,明确病因,骨髓穿刺是确诊白血病的“金标准”,家长无需过度恐惧这项检查,它对宝宝的创伤极小,却是精准诊断的必要手段。
医生最后想说:

如果宝宝出现面色苍白、不明原因出血、反复发热、精神不佳等情况,请立即前往正规医院的儿科、儿童血液科就诊,别让一时的疏忽,留下无法弥补的遗憾。愿每一个小天使都能远离重疾,健康快乐长大!也提醒所有家长,重视儿童血常规检查,守护好宝宝的血液健康,从读懂每一份检查报告开始。

专家简介
李丹 主任医师 医学硕士 小儿血液内分泌科主任
个人简介及专业特长:
1999年毕业于大连医科大学临床医学专业,从事儿科临床工作二十余年,熟练掌握儿科常见病、多发病及疑难重症的诊断及治疗,尤其擅长小儿血液及内分泌系统疾病的诊治。在儿童贫血、血小板减少、凝血功能障碍、EB病毒感染、白血病、淋巴瘤、再生障碍性贫血、儿童糖尿病、甲状腺疾病、性早熟、生长激素缺乏等疾病的诊治方面有丰富的临床经验。曾先后于中国医科大学附属盛京医院和中国医学科学院血液病医院进修学习,发表国家级论文多篇。
社会任职:
1.锦州市医学会儿科分会副主任委员
2.辽宁省医学会儿科分会血液学组副组长
3.辽宁省生命科学学会青春期医学与儿科内分泌专业委员会委员
个人荣誉:
1.锦州市科技进步一等奖
2.锦州市第四批基础学术和技术带头人
3.锦州市巾帼建功标兵等荣誉称号
供稿科室|内三科 文|李丹
图文审核|陈双 王敬然 吴惠敏
编辑制作|姜任龙
图文校对|马明扬 简跃 苏茜 李鹏
医院动态
查看更多- 全力打造营商环境最佳口碑省!... 2026-01-23
- 【安全生产】请查收安全生产小贴士(十二)——《医... 2026-06-15
- 【书香医院】星耀好书 全民共享——我院第二届读书... 2026-06-15
- 【培训招生】2026年产前筛查与产前诊断技术人员... 2026-06-15
信息公开
查看更多- 空气灌肠机的采购公告... 2026-06-04
- 全自动凝血分析仪的采购公告... 2026-06-04
- 锦州市妇婴医院(妇幼保健院)2026年预算公开文... 2026-01-28
- 辽宁省锦州市妇婴医院2024年度部门决算公开... 2025-08-19


